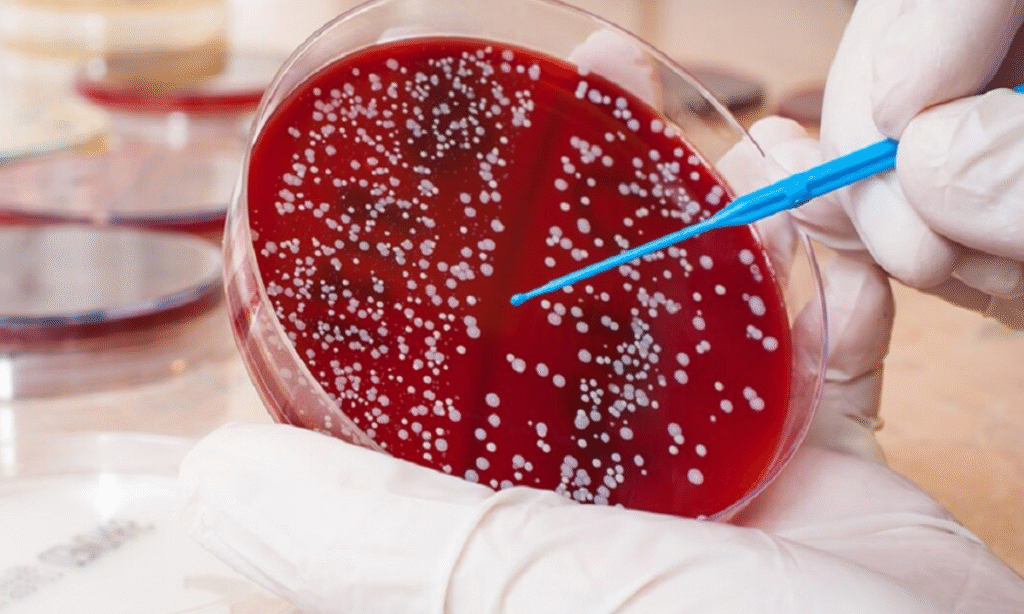

Blood cancer sign is often subtle in the beginning, but understanding them early can make a big difference.
At our cancer hospital in Bangalore, we meet patients who ignored early warning signs for months because they seemed like routine health issues. That’s why awareness is the first step toward timely diagnosis.
In this blog, we will break down blood cancer reason, its signs, symptoms, and modern treatment options. Keep reading, because one section will surprise you about how treatment has evolved in India.
What is blood cancer?

When people ask us, “What is blood cancer?”, we explain that it is a disease that affects how blood cells grow and function. Instead of producing healthy cells, the body produces abnormal ones that crowd out normal cells, weakening immunity and overall health.
Blood cancer occurs when abnormal blood cells grow uncontrollably, disrupting the normal production of red cells, white cells, and platelets.
It is broadly categorized into:
- Leukemia – starts in the bone marrow and blood.
- Lymphoma – begins in the lymphatic system.
- Myeloma – affects plasma cells in bone marrow.
Each type behaves differently, but the signs of a blood cancer often overlap.
Blood Cancer Reason
The exact causes are still being studied. However, common risk factors include:
- Genetic mutations
- Family history of blood cancer
- Exposure to radiation or harmful chemicals
- Weakened immune system
- Viral infections like Epstein-Barr or HTLV-1
While we cannot control genetics, lifestyle and regular check-ups help reduce risks.
Signs of a Blood Cancer
The symptoms for blood cancer are often confused with minor illnesses. Here are some key warning signs:
| Common Signs | Why They Happen |
|---|---|
| Persistent fatigue | Lack of healthy red blood cells (anemia) |
| Unexplained weight loss | Rapid cell growth and energy consumption |
| Frequent infections | Weak immune system from abnormal white cells |
| Easy bruising or bleeding | Low platelet count |
| Night sweats and fever | The body reacts to abnormal cancer cells |
| Swollen lymph nodes | Lymphatic system involvement |
Tip: If these symptoms last more than 2 weeks, consult a doctor without delay.
Symptoms for Blood Cancer: Examples
To make it relatable, let us share an example.
One of our patients thought constant tiredness and nosebleeds were due to stress. A simple test revealed early-stage leukemia. Early detection helped in quicker recovery.
This shows why recognizing blood cancer sign at the earliest is so important.
What is blood cancer treatment?

Treatment depends on the type, stage, and overall health of the patient. Options include:
- Chemotherapy – drugs to destroy cancer cells.
- Radiation therapy – targeted rays to kill or shrink tumors.
- Immunotherapy – boosting the body’s natural defense.
- Targeted therapy – drugs that attack specific cancer genes.
- Bone marrow transplant operation – replacing diseased cells with healthy stem cells.
Stem Cells in Bone Marrow Transplant

Bone marrow is the factory of blood. When damaged, it cannot produce healthy cells.
That’s where stem cells in bone marrow transplant come in. Stem cells can rebuild the blood system, giving patients a second chance at healthy living.
At our cancer hospital in Bangalore, we use advanced bone marrow transplant procedures tailored to each patient’s needs.
Life After Treatment
Patients often ask, “Can a person recover from blood cancer?” The answer is encouraging: many do.
With regular follow-up, a balanced diet, exercise, and emotional support, survivors lead fulfilling lives.
Wrapping Up
Understanding blood cancer sign is the first step in fighting the disease. From knowing the symptoms for blood cancer to exploring the latest therapies like bone marrow transplant operation, awareness can save lives.
If you or your loved ones are seeking trusted care, our cancer hospital in Bangalore is committed to providing expert treatment and compassionate support. At Dasappa Cancer Hospital, we believe that with the right knowledge and timely care, hope is always possible.
FAQs on Blood Cancer
1. What is the first stage of blood cancer?
The first stage usually involves abnormal blood cell growth in bone marrow with mild symptoms like fatigue or infections. Early detection here improves treatment success rates.
2. What is the survival rate for blood cancer?
Survival rates depend on type and stage. With modern treatments like bone marrow transplant, many patients achieve long-term remission and a good quality of life.
3. Can a person recover from blood cancer?
Yes, recovery is possible. Advances in chemotherapy, immunotherapy, and stem cell transplant have made complete recovery achievable for many patients across the world.
4. How do I know if I have cancer in my blood?
Look out for signs such as fatigue, frequent infections, bruising, and unexplained weight loss. Only blood tests and medical evaluation confirm the diagnosis.5. Is blood cancer hereditary?
Some genetic factors increase risk, but not all cases are inherited. Lifestyle, infections, and environmental exposure also play major roles in development.





